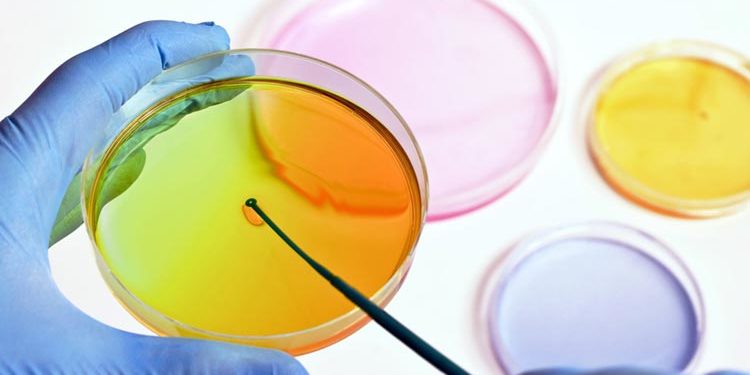
Reach Ministero Sviluppo Economico Buone Pratiche

Indagine sulle buone pratiche delle imprese italiane “Innovazione sostenibile e inclusiva e rendicontazione non finanziaria nel quadro dell’Agenda 2030”.
Risposte entro il 29 novembre 2017
Il Ministero dello Sviluppo Economico – Punto di Contatto Nazionale per l’attuazione delle Linee Guida OCSE per le imprese multinazionali in materia di condotta di impresa responsabile, e l’Help-desk REACH, promuovono l’indagine conoscitiva sulle buone pratiche delle imprese italiane “Innovazione sostenibile e inclusiva, e rendicontazione non finanziaria nel quadro dell’Agenda 2030”, nell’ambito delle azioni inerenti i temi di Sviluppo Sostenibile e della rendicontazione non finanziaria, analizzati in un’ottica di implicazioni per le imprese nella predisposizione di strategie, meccanismi e processi innovativi, in linea con le policy pubbliche.
Il questionario mira anche ad identificare esempi di imprese che, nelle proprie attività, hanno intrapreso un percorso di sostituzione delle sostanze SVHC con altre meno pericolose.
Una gestione delle sostanze chimiche rispettosa di ambiente e salute, infatti, è elemento decisivo per il raggiungimento di alcuni degli obiettivi di sviluppo sostenibile (Sustainable Development Goals).
L’indagine rappresenta il primo passo di un percorso che porterà alla stesura di un rapporto di sintesi a cura del MiSE i cui elementi chiave costituiranno la descrizione delle pratiche d’impresa in un’ottica aziendale integrata.
Il questionario può essere compilato e inviato entro il 29 novembre 2017 al seguente indirizzo di posta elettronica pcn1@mise.gov.it.
Fonte Reach Sviluppo Economico